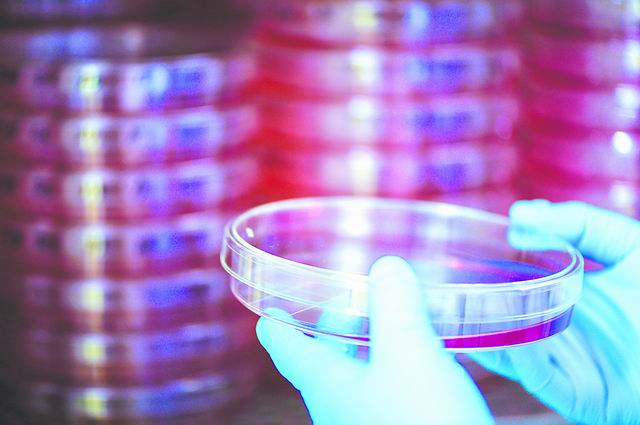
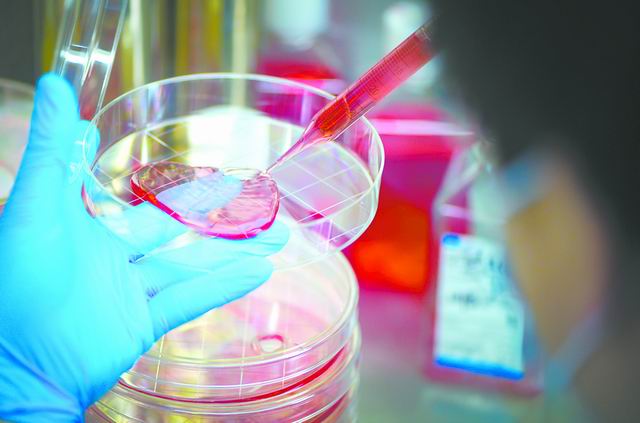

来源: 中国科学报
作者:冯丽妃

①高福(右1)指导学生做实验

②严景华在观察细菌菌落状态

③施一(右2)指导学生做实验
④科研人员在观察细胞
⑤研究人员在做哺乳动物细胞实验

⑥“致微”雕塑,该雕塑是一个被打开的艺术化处理的流感病毒,为了纪念以中国科学院为核心的科研团队,在抗击流感事业中作出的贡献

⑦微生物所与亚宝药业就“抗新冠病毒抗体技术”签订合作协议 本版图片由病原室供图
■本报记者 冯丽妃
5月中旬的一天,晚9时许,中国科学院院士高福步履匆匆地走进位于北京奥运村的中国科学院微生物研究所(以下简称微生物所)。依托该所建立的中国科学院病原微生物与免疫学重点实验室(以下简称病原室)是高福做科研的一个主战场。他担任该实验室主任已逾十年。
国内新冠肺炎疫情余烬仍在,作为中国疾控中心主任,高福每天的日程表都超载,他只能在晚上给课题组开会,和大家一起沟通新进展,策划研究方向。
几个月来,病原室战“疫”捷报频传。而这一切则得益于多年沉淀。
经过十余年的发展,病原室在病毒跨种机制传播研究等方面已走在国际最前沿。不过,高福依旧时刻“敲打”和“鞭策”室里的研究人员:“必须保持清醒头脑,如果不努力就会掉队,成为龟兔赛跑中的那只兔子。”
平战结合 直面大考
1月下旬,一场突如其来的新冠肺炎疫情给鼠年春节蒙上了巨大阴影,疫情变化牵动着公众的心。作为科技“国家队”的一员,微生物所以病原室为核心,从新冠病毒溯源、传播机制研究到快速检测技术测试,再到抗体和疫苗研制、病毒数据库建设等,迅速进行多方位、全链条布局。
面对疫情大考,微生物所每个科研人员都拧紧了心里的发条。他们把实验室当成了家,夜以继日、加班加点。“大家都很拼命。”回顾4个多月来走过的路,微生物所所长钱韦如是说。
此次疫情攻关,严景华和高福团队承担了科技部疫苗攻关5条路线之一的重组蛋白疫苗,以及新冠肺炎抗体药物的研究。面对民众对药物和疫苗的渴求,这两个项目给科研人员带来了巨大压力。为了快些出结果,研究员王奇慧甚至累到出现高频失聪。
经过连续数月“冲刺”,严景华、高福、王奇慧合作团队不负重望,不断传出好消息。6月5日,微生物所和君实生物联合研发的新冠病毒全人源单克隆抗体的临床试验获国家药监局批准,这是全球首个完成非人灵长类动物实验后,在健康人群中开展的新冠肺炎治疗性抗体临床试验。同时,高福与首都医科大学、中科院北京生命科学研究院等机构研究者合作分离出的另外一组人源性抗体,也已进入临床前试验阶段。
6月19日,微生物所研发的新冠重组蛋白疫苗获批开展Ⅰ期临床试验。有别于此前获批进入临床试验的腺病毒载体疫苗和灭活疫苗,这是一种新技术路线研制的新冠病毒疫苗,其特点是将一个病原体最有效的抗原成分基因拿出进行体外重组,然后制成疫苗。最近,微生物所第二款疫苗——重组黑猩猩腺病毒载体新冠疫苗,也已与企业达成协议共同开发,目前处于临床前准备阶段。
至此,微生物所的两组人源性抗体、两款疫苗,正向前迈进。
不仅如此,上述研究成果还先后发表于《自然》《细胞》《科学》等杂志,其中抗体研究转化产出超2亿元,实现了从基础研究到经济效益的跨越。“产学研结合非常重要,要想做好转化,一开始就要奔着产品去。”严景华告诉《中国科学报》,在此次疫苗、抗体研发之初,课题组就利用此前建立的合作关系,邀请企业参与。“否则,实验室做的东西没办法快速转化成产品。”
与此同时,病原室其他成果也捷报频传:施一团队揭示了新冠病毒核心聚合酶复合物的近原子分辨率结构;齐建勋团队解析了新冠病毒RBD与人体ACE2复合物的晶体结构;毕玉海团队率先研制新冠病毒核酸检测试剂盒,捐赠全国各地2万余份;作为构成疫苗必备的抗原、佐剂两大要素之一,孟颂东团队研制的目前唯一用于临床的天然佐剂——gp96介导的T细胞佐剂已达到临床生产级别,成为疫苗研发的技术储备。
此外,温廷益团队合成的全球首款“尼龙56”材料8月底在黑龙江投产,日产量足以制作数百万套防护服,弥补了生物安全防控中通常缺失的“防护”研究一环。需要指出的是,该材料打破了长久以来美国“尼龙66”的技术垄断,不仅具有阻燃性,还具有吸湿性、易染色以及原材料价格低廉等特点,是制作军装、医用防护服等的理想材料。温廷益介绍,最近这项从玉米到服装材料的原创技术已经转化,转让费为1.2亿元。
“做研究一定要平战结合,‘平’时干的事要能解决‘战’时的需求。”高福强调。
与疫情短兵相接,病原室交出了一份沉甸甸的“成绩单”。而支撑起这次微生物所抗疫全链条联动的,则是实验室十余年的创新与沉淀。
顶天立地 与国共振
“中国科学家如果不去解决中国社会发展需求所对标的科学问题,那就不是真正的科学家。”高福说,“科学问题一定要和社会问题有效对接,研究成果或是走上书架,进入教科书;或是走上货架,变成产品,解决实际需求。”
在高福看来,这也是病原室的使命与存在的意义。
病原室的历史可追溯至1958年微生物所建所时成立的病毒学研究室,当时的研究以植物病毒为主。上世纪90年代,在人类健康和社会安全的背景下,中科院院士田波带头建立分子病毒学和生物工程开放实验室,向动物病毒学方向发展。2004年,高福与刘文军的回归让这一方向的力量开始壮大。
“最初只有‘两三杆枪’,没有什么高大上的仪器设备,也没有像样的文章。只要有人来应聘,立马就招了。”谈起回国之初共同创建实验室的场景,病原室副主任刘文军仍历历在目。在关键的学科定位上,考虑到SARS之后我国病原微生物研究领域的不足等问题,两人把主攻方向定在病原微生物与免疫领域,成立了分子病毒中心和分子免疫中心。
2005年,高福等人关于青海湖水禽感染禽流感H5N1的研究成果发表于《科学》,这是世界上首次描述水禽群体感染禽流感病毒后大量死亡的研究,受到国际关注。同时,刘文军在动物干扰素方面的研究也开始产出成果,获得应用专利。这些成果为此后病原室学科发展打下基础。
2008年,在微生物所学科凝练的背景下,分子病毒学和生物工程开放实验室与分子病毒中心和分子免疫中心合并,病原室应运而生,并升级为中科院重点实验室。病原室也逐渐凝练出病原生物和微生物组、免疫生物学和肿瘤免疫以及药物、疫苗与细胞治疗三大研究方向。
“所有研究方向都是为了解决制约中国经济社会发展的‘卡脖子’加‘卡脑子’问题。”高福表示,3个方向回答的问题具有内在关联性。禽流感、新冠等病毒为什么跨种传播?病毒与宿主的互作,人体如何免疫?有哪些药物、疫苗、疗法可以防治病毒?回答这些问题,前两个方向更倾向于基础研究,而第三个方向则偏重应用研究。
对此,钱韦表示,病原室最大的发展优势就是和国家同频共振,很好地结合了国家重大战略需求。自2008年起,所有针对国内外新发突发传染病的研究攻关,都看得见病原室的身影——禽流感、猪流感、中东呼吸综合征、埃博拉病毒、寨卡病毒,一场场科研攻关战练就了病原室对疫情的各项应战能力。
面对新冠肺炎疫情,整个病原室研究的快速推进,也是因为这些积累。
如今的病原室已从最初的“两三杆枪”发展到“十多杆枪”,拥有19个研究团队以及P3实验室等一批先进支撑平台,在新发突发传染病、肝炎、结核、肿瘤和自身性免疫疾病研究方面取得了重要突破,实现了《细胞》《自然》《科学》《柳叶刀》《新英格兰医学期刊》等国际顶刊文章的“大满贯”,同时,产业转移转化经济收入达到5亿元。
近年来,实验室对成果转移转化愈加重视。如刘文军课题组的动物干扰素专利已转让1000多万元,这些干扰素或可治疗动物传染病,或可替代抗生素实现绿色养殖,取得了国际认可;孟颂东课题组基于多年乙肝研究,找到52种抑制肿瘤的抗原,目前课题组已获得公益基金捐款,在小规模肝癌和胰腺癌临床研究方面初见成效;温廷益课题组依托微生物所,与宁夏、南京、浙江等地政府或企业建立研究院,推动生物基戊二胺及尼龙56、L—丙氨酸(广泛应用于食品、保健和医药产业)、N—月桂酰L—丙氨酸(新一代绿色去污合成化合物)等高附加值成果落地开花……
“微生物、高科技、大产业”,病原室用一项项实实在在的成果阐释着微生物所人的这一愿景。
“一个好的实验室要有进有出,学会自己造血,不能光靠国家的财政拨款。”温廷益说。依托微生物所和病原室,温廷益与宁夏、南京、浙江等地政府或企业联合建立的研究院正在推动多项成果走出实验室,走进大众生活。
开展病原微生物、人体肠道微生物菌群研究的研究员朱宝利也赞同这一观点。“如果我们能够跟企业联合,把产业这块做起来,也可以给青年人补贴一点儿,不然优秀的人才签不到所里来。”他坦言。
和而不同 创新跨越
经过十余载跨越发展,病原室的研究已跨入国际第一方阵,特别是在新发突发传染病领域,吸引了许多国际一流科学家合作。不过,对于这个年轻的实验室来说,一切才刚刚开始——病原室人心中的“一流”没有止境。
对这个充满潜力的实验室,中科院、微生物所也寄予厚望。“十三五”期间,病原室作为主体承担了中科院战略性先导专项(B类)“病原体宿主适应与免疫干预”,致力于在流感通用疫苗、感染及感染诱发肿瘤的免疫疗法和新发再发传染病的早期预警预测等方面取得突破性成果。同时,在微生物所围绕“生命与健康”打造的从源头创新、核心技术到产业转化的完整创新价值链条中,病原室也发挥了重要作用。
“在建立生物安全大科学中心的背景下,未来一段时间,微生物所会以大安全、大健康为战略方向,朝着符合国家重大战略需求的发展方向去努力。”钱韦说。病原室的研究将为实现这一目标提供重要支撑。
病原室的明天会怎样?在钱韦看来,关键在人。在青年人才选拔方面,微生物所不拘一格,无论是本土培养人才,还是海归人才,“英雄不问出处”,一切以品德和能力为重。为培养青年科研骨干,该所还启动了“青年研究组长”特色计划,一旦获得支持,青年人员在副研究员时期就可以“独立”,并获得独立实验室、启动经费、研究生指标等资源倾斜。
“通过这样的环境,我们希望他能在这里从一个士兵变成将军。”钱韦补充说。
“85后”研究员施一就是微生物所和病原室培养的这样一名“将军”。因在病原研究方面的成绩,他30岁就被聘为研究员,创下了研究所乃至中科院当时最年轻研究员的纪录。2018年施一担任病原室副主任,2019年至今又先后担任微生物所党委委员和所务委员,这都是微生物所通过“压担子”培养年轻人。
“实验室已经形成了较好的人才梯队,目前45岁以下青年人才占比超过77%,平均年龄39岁。”施一介绍。其中包括国家杰出青年基金获得者2名,国家优秀青年基金获得者4名。
“科研最大的快乐是自由生长、独立探索。”刘翠华从美国哈佛回国后,先后在中国医学科学院基础所、解放军第309医院等多个机构做研究,2010年她以青年研究组长的身份被引进微生物所,获得独立的机会。她如此表示。
因带领研究组在结核病研究方面做出突出成绩,2018年,刘翠华获得年度国家杰出青年科学基金项目资助,并入选国家万人计划科技创新领军人才。2019年她也被任命为病原室副主任。在她看来,中科院是做研究最好的“品牌机构”。“科研是有传承的,在这个过程中受到的影响会让人受益终身。”
和而不同,跨越创新。这是病原室凝练的室训。“和而不同,是希望每个研究组都有自己独立的学术方向,同时又能融合起来大兵团作战;跨越创新,是要把握住各种机遇,凝练科学问题,做好研究。”刘文军说。
“最初实验室的目标就是国际一流,但我确实没想到(我们)会做到这么好。”高福说。另一方面,科研创新没有尽头,他希望病原室的研究者继续努力,严格要求自己,保持头脑清醒。
“如果不努力就会掉队。”高福说。
科研路上情浓时
时间回溯到2009年,病原室刚成立不久,施一尚在该实验室读博。他记得一天晚上在密云开年会时,在高福的倡议下,实验室的老师、学生们挨个上台谈科研理想,谈未来两三年内期望实现的突破,谈自己能为新生的重点实验室做些什么。
“尽管当时没有意识到自己会不会做出重要的突破性研究,但我也上去了,大声说‘我要发Science’。”回顾那一刻,施一笑着说,“其实我也不知道自己能不能做到,但我觉得先要有目标。敢想,才会抓住机遇。”
那一刻,是激情,推动着施一等人说出自己的理想。十年筑梦,施一已经兑现了那天晚上对自己的承诺——他和团队在病原微生物方面的研究多次发表于《科学》《自然》《柳叶刀》等顶刊。
时间再回到2004年,在美国GENZYME公司工作的刘文军回国探亲,听说老同学高福也从英国回来了,两人便相约在清华大学附近的一个小酒吧见面。刘文军与高福是同窗校友,上世纪80年代均在北京农业大学读硕士,那时起就结下了友谊。
老友相见,一聊就到大半夜。结果是,9月底刘文军步高福后尘,加盟微生物所。
那一刻,是豪情,推动着刘文军做出如此决定——16年来,同窗成了战友,一个战壕里工作,困境中守望相助,成就了病原室的一路向好。
病原室人眼中的“精神领袖”高福,被大家公认为超级“工作狂”:“他组会已经开到凌晨两点,早上6点又去上班了。”“高老师上车补觉,到所里就开始看(论文),完了就叫人讨论。”“这栋楼你应该看一下,晚上有多少个做科研的是他们组的。”……
同事、学生眼中高福的“严”与“拼”,是缘于他心底深处的热情:一定要培养出事业的传承者。
这次走进病原室,《中国科学报》采访了12位研究人员,科研路上的浓情时刻还有很多。比如在此次疫情中,青年研究员王军在奔赴武汉时的不假思索,王奇慧面对任务昼夜奋战累到几乎失聪,齐建勋、毕玉海等以实验室为家分析病毒、研究检测试剂……
透过这些浓情时刻,我们感受到了他们对科研的那份坚持和信念。(冯丽妃)
中科院病原微生物与免疫学重点实验室简介
中国科学院病原微生物与免疫学重点实验室成立于2008年12月,2016年在中国科学院重点实验室评估中评估优秀,且成绩位列生物领域第一名。实验室的依托单位是中国科学院微生物研究所。
实验室面向国家战略需求,坚持以问题为导向,经过十余年的发展,已经成为国际一流的病原微生物研究平台。目前,实验室拥有19个研究组,聚焦病原生物和微生物组、免疫生物学和肿瘤免疫以及药物、疫苗与细胞治疗三大研究方向,在新发突发传染病、肝炎、结核、肿瘤和自身性免疫疾病研究方面取得了重要突破,为我国重大传染病的防治提供科技支撑,并推动成果的转移转化及相关技术产业的快速发展。

 豫公网安备 41040302000058号
豫公网安备 41040302000058号
